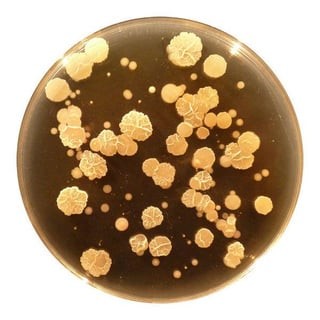
image

TIL that Christopher McDonald declined playing Shooter McGavin twice because he was tired of playing villains and he wanted to spend time with his family. He became interested in the role after winning a round of golf.
#til #todayilearned
https://www.reddit.com/r/todayilearned/comments/1qy6rwn/til_that_christopher_mcdonald_declined_playing/


Happy Gilmore - Wikipedia